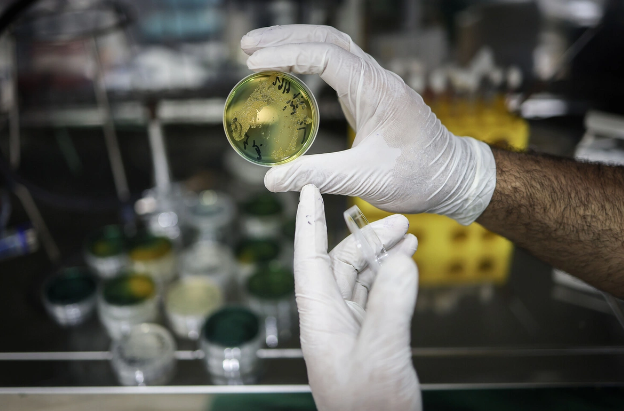
Super bakteriyanın "yürüşü": Alimlər antibiotikləri qəbul etməyən yeni vəba ştamı aşkarlayıblar

Super bakteriyanın "yürüşü": Alimlər antibiotikləri qəbul etməyən yeni vəba ştamı aşkarlayıblar
 Alimlər 10 müxtəlif antibiotikə qarşı davamlılıq göstərən vəba ştamı müəyyən ediblər.
Alimlər 10 müxtəlif antibiotikə qarşı davamlılıq göstərən vəba ştamı müəyyən ediblər.
Oxu.Az xəbər verir ki, bu barədə Paster İnstitutunun Vibrion və Vəba üzrə Milli İstinad Mərkəzinin alimləri məlumat yayıblar. Tədqiqatların nəticələri "New England Journal of Medicine' (NEJM) jurnalında dərc edilib.
Məlumata görə, "Vibrio cholerae" adlanan təhlükəli ştam ilk dəfə 2018-2019-cu illərdə Yəməndə baş verən vəba epidemiyası zamanı aşkarlanıb. Bakterial genomların sekvensləşdirilməsi metodu tədqiqatçılara ştamın ölkələr arasındakı yolunu və yayılmasını dəqiq izləmək imkanı verib.
Yəməndən sonra bu ştam 2022-ci ildə Livanda, 2023-cü ildə isə Keniyada qeydə alınıb. 2024-cü ilə qədər ştam Tanzaniya, Komor adaları və Fransanın Mayotta adasına da yayılıb. 2024-cü ilin mart ayından iyul ayına qədər Mayotta adasında bu ştamın səbəb olduğu 221 vəba hadisəsi qeydə alınıb.
Xüsusi narahatlıq doğuran məqam odur ki, bu ştam vəbanın müalicəsində istifadə olunan iki əsas antibiotik - azitromisin və siprofloksasinə qarşı davamlılıq nümayiş etdirir. Əgər o, tetrasiklinə qarşı da davamlılıq qazanarsa, xəstəliyin effektiv müalicəsi əhəmiyyətli dərəcədə çətinləşəcək.
Ekspertlər vəba törədicilərinin antibiotiklərə qarşı davamlılığında baş verən dəyişikliklərin vaxtında aşkarlanması üçün gücləndirilmiş qlobal monitorinqin vacibliyini vurğulayıblar. Onların fikrincə, bu təhdidlərə operativ reaksiya vermək və genişmiqyaslı epidemiyaların qarşısını almaq mümkündür.
Sonxeber.az
 Telegramda izləyin
Telegramda izləyin
Maraqlı Baxılıb: 991 Tarix: 18 dekabr 2024
Şikayətiniz varsa Whatsapp: 077 7125666
Facebookda Paylaş
Yer kürəsi niyə yarıya bölünəcək? - Alimdən maraqlı açıqlama
Sakit okeanda, Vankuver adası sahillərində Şimali Amerika tavasının altına Xuan-de-Fuka və Eksplorer plitələrinin çökməsi (subduksiya) prosesi hazırda qeyri-adi şəkildə davam edir. Bu geoloji dəyişiklik uzaq gələcəkdə planet üçün ciddi təhlükələr yarada bilər. xəbər verir ki, bu barədə "LAD Bible"
6 may"Vilyareal" klubundan gözlənilməz qərar
İspaniyanın "Vilyareal" klubu cari mövsümün sonunda baş məşqçi Marselino Toralın komandanı tərk edəcəyini rəsmən açıqlayıb. xəbər verir ki, bu barədə klub "X" sosial şəbəkəsindəki hesabında yaydığı bəyanatda bildirib. "Bu klub və onun azarkeşləri üçün etdiyin hər şeyə görə sən
4 mayGənc qızın küçənin ortasında etdiyi rəqs tənqidlərə səbəb oldu - VİDEO
Son dövrlərdə xüsusilə xarici ölkələrdə populyarlaşan küçədə rəqs videoları Türkiyədə də gündəm mövzusuna çevrilib. xarici mediaya istinadən xəbər verir ki, sosial mediada paylaşılan görüntülərdə gənc bir qadının İstanbul küçələrindən birində musiqi sədaları altında rəqs etdiyi və ətrafdakı insanları
7 maySinqapurda intizamı pozan məktəblilərə QEYRİ-ADİ CƏZA
Sinqapurun orta məktəblərində intizamı pozan oğlan şagirdlər üçün sərt fiziki cəzaları nəzərdə tutan yeni qaydalar qüvvəyə minib. xəbər verir ki, bu barədə "The Guardian" nəşri məlumat yayıb. Məlumata görə, fiziki zorakılıq da daxil olmaqla, ciddi nizam-intizam qaydalarını pozan məktəblilər
7 may90 yaşlı nənələrin idman zalında etdiklərini görənlər şok oldu - VİDEO
Tayvanda 89 və 91 yaşlı iki qadının idman zalında etdiyi məşqlər diqqət çəkib və sosial mediada maraqla qarşılanıb. xarici mediaya istinadən xəbər verir ki, irəli yaşlarına baxmayaraq mütəmadi şəkildə idmanla məşğul olan qadınlar fiziki aktivlikləri ilə bir çoxlarına nümunə olub. Onların məşq zaman
4 mayNarazı gəlin diqqət çəkdi - VİDEO
Toy məclislərindən birində lentə alınan görüntülər sosial şəbəkələrdə müzakirələrə səbəb olub. xəbər verir ki, yayılan kadrlarda ən çox diqqət çəkən məqam gəlinin üz ifadəsi olub. İzləyicilər onun narazı və bir qədər soyuq göründüyünü qeyd ediblər. Görüntülərdə cütlüyün rəqs etdiyi anlar da yer alıb
3 mayBu ölkədə ət reklamları yığışdırıldı
Niderlandın paytaxtı Amsterdam şəhərinin rəhbərliyi ət və qazıntı yanacağı məhsullarının küçə reklamına tarixi qadağa tətbiq edərək, dünyada belə bir qərar qəbul edən ilk paytaxt olub. xarici mediaya istinadən xəbər verir ki, mayın 1-dən etibarən burger və aviabilet reklamları lövhələrdən, eləcə də avtobu
5 may Alimlər 10 müxtəlif antibiotikə qarşı davamlılıq göstərən vəba ştamı müəyyən ediblər.
Alimlər 10 müxtəlif antibiotikə qarşı davamlılıq göstərən vəba ştamı müəyyən ediblər. Telegramda izləyin
Telegramda izləyin












 Aldığı təzə avtomobili ekspertizaya aparan kişi həyatının şokunu yaşadı
Aldığı təzə avtomobili ekspertizaya aparan kişi həyatının şokunu yaşadı Qurduğu sistemlə 40 dəqiqəlik yolu 40 saniyəyə endirdi: "Sən dəlisən?" deyənlər də oldu - FOTO
Qurduğu sistemlə 40 dəqiqəlik yolu 40 saniyəyə endirdi: "Sən dəlisən?" deyənlər də oldu - FOTO Üç nəhəng bənd və süni göl: Səudiyyə Ərəbistanı imkansızı yaradır
Üç nəhəng bənd və süni göl: Səudiyyə Ərəbistanı imkansızı yaradır Bu ərazilərdə qaz kəsiləcək - Xəbərdarlıq
Bu ərazilərdə qaz kəsiləcək - Xəbərdarlıq Vüsal Nəsirli generalın oğlunu işdən çıxardı
Vüsal Nəsirli generalın oğlunu işdən çıxardı Hava kəskin dəyişəcək, yağıntı intensivləşəcək
Hava kəskin dəyişəcək, yağıntı intensivləşəcək Baş nazir bəzi həkimlərin maaşı ilə bağlı QƏRAR İMZALADI
Baş nazir bəzi həkimlərin maaşı ilə bağlı QƏRAR İMZALADI Mövlud Çavuşoğlunun qardaşı güllələndi
Mövlud Çavuşoğlunun qardaşı güllələndi Görünüşə görə qapıdan qaytardılar
Görünüşə görə qapıdan qaytardılar Boşanma davası açdığı həyat yoldaşından gələn mesaj qadını şoka saldı - FOTO
Boşanma davası açdığı həyat yoldaşından gələn mesaj qadını şoka saldı - FOTO Qəbiristanlıq yaxınlığında tapılan azyaşlının anası erkən evliliyin qurbanı olub: Dəhşətli faktların üstü açıldı - VİDEO
Qəbiristanlıq yaxınlığında tapılan azyaşlının anası erkən evliliyin qurbanı olub: Dəhşətli faktların üstü açıldı - VİDEO "Ağıl və ürək dilemması daxili qarışıqlığın əlamətidir" - PSİXOLOQ
"Ağıl və ürək dilemması daxili qarışıqlığın əlamətidir" - PSİXOLOQ Xərçəngə qalib gələn şagird olimpiadada qızıl medal qazandı
Xərçəngə qalib gələn şagird olimpiadada qızıl medal qazandı 7 yaşlı uşağı qaçırıb öldürən kuryerə ölüm cəzası verildi - VİDEO
7 yaşlı uşağı qaçırıb öldürən kuryerə ölüm cəzası verildi - VİDEO